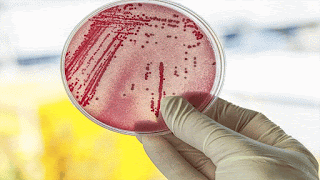

SUPERBUG SPREAD IS LINKED TO INTAKE OF SUGAR
Prof Dr,DRAM,HIV /AIDS,HEPATITIS ,SEX DISEASES & WEAKNESS expert,New Delhi,India, +917838059592
If we take more sugar beside being causing diabetes and its allied complication it also leads to spread of a superbug too.A dietary sugar approved as a food additive for use in foods from sushi and vegetables to ice cream may have fuelled the frequency and severity of a deadly superbug, scientists say.
The findings showed that trehalose, used in foods as a sweetener, a stabiliser and thickener, as well as a flavour enhancer, enhanced the virulence of bacterium Clostridium difficile (C. difficile ) -- a bacterium that can cause life-threatening inflammation of the colon and diarrhoea.C. difficile lineages RT027 and RT078 were found to become dominant more recently around the globe.
These lineages grew on low concentrations of trehalose as a sole carbon source and are highly efficient at independently acquiring unique mechanisms to break down low concentrations of trehalose."In 2000, trehalose was approved as a food additive in the US for a number of foods from sushi and vegetables to ice cream, and about three years later the reports of outbreaks with these lineages started to increase," said Robert Britton, Professor at Baylor College of Medicine.
These lineages grew on low concentrations of trehalose as a sole carbon source and are highly efficient at independently acquiring unique mechanisms to break down low concentrations of trehalose."In 2000, trehalose was approved as a food additive in the US for a number of foods from sushi and vegetables to ice cream, and about three years later the reports of outbreaks with these lineages started to increase," said Robert Britton, Professor at Baylor College of Medicine.
For the study, appearing in the journal Nature, the team gave mice with C. difficile infection a strain of the RT027 lineage of C. difficile and a diet with or without low trehalose levels. "What the mice ate made a difference to the virulence of the infection, mortality was higher in the group consuming trehalose," said James Collins, a postdoctoral associate at the varsity.
The RT027 bacterial load in the mice was the same regardless of whether they were fed this sugar or not.Instead what made the disease more severe was that RT027 produced higher levels of toxins, making the bacteria far more virulent, the researchers said.
"Our study suggests that the effect of trehalose in the diet of patients in hospitals with RT027 and RT078 outbreaks should be further investigated," Collins said.
- Kidney stones universally present hazard in north india,dillution by water prevent it
- Steroid and placebo effect equally for mild persisting asthma with low sputum eosinophils
- Government wants to fix public healthcare staff shortages with ayush docs: will it work?
- Plea in hc for payment of salaries of edmc, north mcd teachers and doctors
- 7 indian pharma companies named in us lawsuit over inflating generic drug prices
- Woman in up dies after explosion in her mouth during treatment,what is diagnosis?
- Woman in up dies after explosion in her mouth during treatment,what is diagnosis?
- Woman in up dies after explosion in her mouth during treatment,what is diagnosis?
- Air pollution ! mothers organising rally in london,anaesthetist choosing gas,will india follow?
- Cardiac arrest is always not sudden as understood -a study

 Comments (
Comments ( Category (
Category ( Views (
Views (